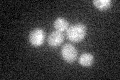
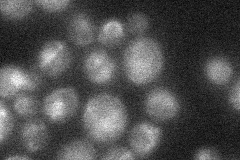

View description
Peptidyl-prolyl cis-trans isomerase (cyclophilin), catalyzes the cis-trans isomerization of peptide bonds N-terminal to proline residues; has a potential role in the secretory pathway
Localization:
Intensity:
Fold change:
Significance:
-
C’ GFP library in SD
below threshold19.86 -
N' NOP1pr-GFP in SD

ER,punctate,vacuole84.5456 -
N' TEF2pr-mCherry in SD

vacuole33.1486 -
N' NATIVEpr-GFP in SD
ambiguous,vacuole24.2568 -
N' TEF2pr-VC and Cyto-VN in SD

#N/A0 -
C’ GFP library in SD+DTT

cytosol25.691.29No -
C’ GFP library in SD+H2O2

cytosol18.10.91No -
C’ GFP library in Starvation Media

cytosol20.241.01No -
C’ GFP library on the background of Pup2-DaMP

below threshold -
C’ GFP library on the background of CCT mutant

below threshold17.24660.867617No
